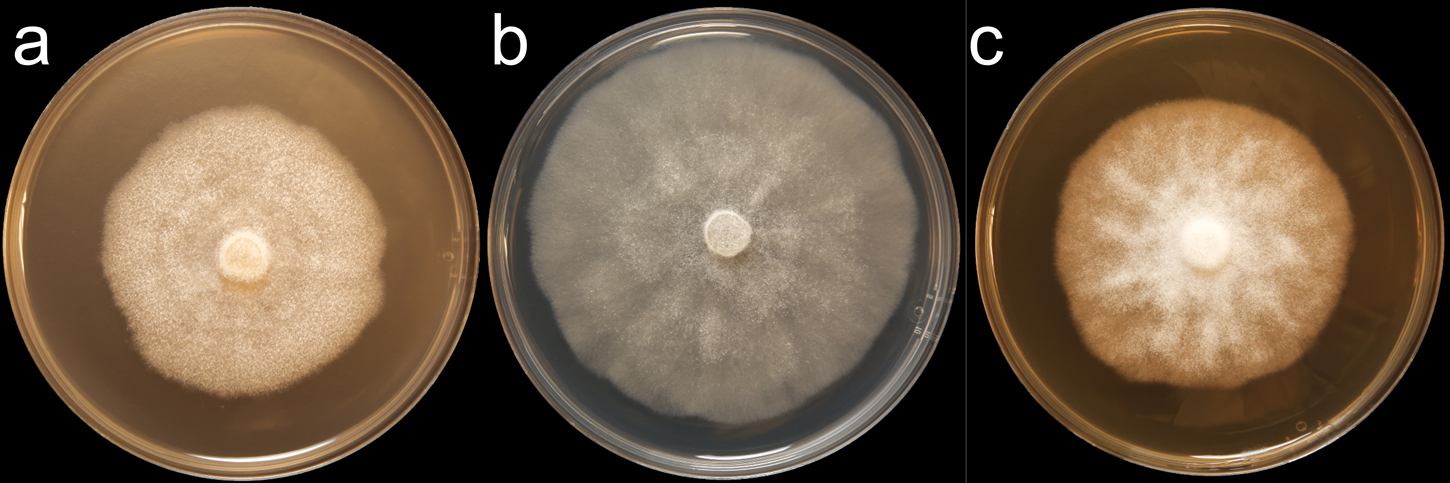
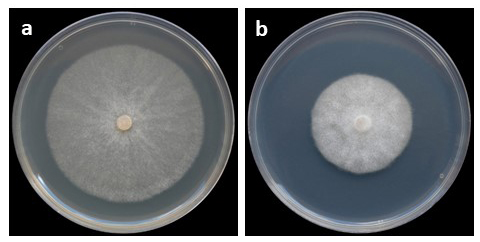

Phytophthora ornamentata
|
Phytophthora spp. in subclade 6b: portion of the seven-loci ML phylogeny featuring the type cultures of 212 described species (by T. Bourret). Notice the position of P. ornamentata Ex-type CBS 140647 = S&T BL 152. Gloria Abad, USDA S&T.
|
|
Phytophthora spp. in subclade 6b: Morphological Tabular key (PDF) and Tabular key legends (PDF) in IDphy2 KEY SECTION. Notice the data of P. ornamentata Ex-type CBS 140647 = S&T BL 152. Gloria Abad, USDA S&T.
|
|
Phytophthora ornamentata (CPHST BL 152) colonies of the ex-type grown for 7 days on (a) V8® Agar, (b) potato dextrose agar, and (c) malt extract agar; photo by Krysta Jennings and Leandra Knight, USDA-APHIS-PPQ |
|
Phytophthora ornamentata colony morphology of the ex-type (PH152 – Bruno Scanu) grown for 5 days at 20°C on (a) carrot agar, (b) potato dextrose agar; photos by Bruno Scanu and Antonio Franceschini, Università degli Studi di Sassari, Italy |
|
Phytophthora ornamentata morphology of the ex-type (PH152 – Bruno Scanu): (a–c) asexual phase, (a) mature nonpapillate elongated persistent sporangium; (b) elongated sporangium showing internal proliferation; (c) globose to subglobose hyphal swellings with radiating hyphae; (d, e) sexual phase, ornamented oogonium, (d) with amphigynous antheridium; (e) with paragynous antheridium and finger-like projection; photos by Bruno Scanu and Antonio Franceschini |
|
extensive dieback and mortality of Pistacia lentiscus caused by Phytophthora ornamentata in Sardinia, Italy; photo by Bruno Scanu, Università degli Studi di Sassari, Italy |
Name and publication
Phytophthora ornamentata Scanu, Linald. & T. Jung (2015)
Scanu B, Linaldeddu BT, Deidda A, and Jung T. 2015. Diversity of Phytophthora species from declining Mediterranean maquis vegetation, including two new species, Phytophthora crassamura and P. ornamentata sp. nov. PLoS ONE 10 (12): e0143234. Doi:10.1371/journal.pone.0143234
Corresponding author: bscanu@uniss.it
Nomenclature
from Scanu et al. (2014)
Mycobank
Etymology
refers to the ornamentation of the oogonial wall
Typification
Type: ITALY, Sardinia. Isolated from rhizosphere soil collected beneath declining Pistacia lentiscus; collected: B. Scanu, 2012; CBS H-22393 (holotype, dried culture on CA, Herbarium CBS-KNAW Fungal Biodiversity Centre)
Ex-type: CBS 140647 = PH152 (culture ex-type)
Sequences for ex-type: Phytophthora ornamentata isolate PH152 ITS rDNA KP863496, cox1 KP863486
Ex-type in other collections
(ET) CBS 140647, PH152, S&T BL 152 (Abad), WPC P19906, 66D2 (Hong)
Molecular identification
Voucher sequences for barcoding genes (ITS rDNA and COI) of the ex-type (see Molecular protocols page)
Phytophthora ornamentata isolate CPHST BL 152B (= P19906 WPC) = ITS rDNA MG865556, COI MH136947
Voucher sequences for Molecular Toolbox with seven genes (ITS, β-tub, COI, EF1α, HSP90, L10, and YPT1
(see Molecular protocols page) (In Progress)
Voucher sequences for Metabarcoding High-throughput Sequencing (HTS) Technologies [Molecular Operational Taxonomic Unit (MOTU)]
(see Molecular protocols page) (In Progress)
Sequences with multiple genes for ex-type in other sources
- NCBI: Phytophthora ornamentata CPHST BL 152B
- NCBI: Phytophthora ornamentata PH152
- EPPO-Q-bank: Phytophthora ornamentata
- BOLDSYSTEMS: Phytophthora ornamentata
Position in multigenic phylogeny with 7 genes (ITS, β-tub, COI, EF1α, HSP90, L10, and YPT1)
Clade clade:
a taxonomic group of organisms classified together on the basis of homologous features traced to a common ancestor
6b
Morphological identification
adapted from Scanu et al. (2014)
Colonies and cardinal temperatures
Colony colony:
assemblage of hyphae which usually develops form a single source and grows in a coordinated way
morphology after 7 days on PDA, CMA, and MEA with no distinct pattern. Minimum growth temperature 5°C; optimum 25°C, and maximum 33°C.
Conditions for growth and sporulation
Phytophthora ornamentata produces sporangiasporangia:
sac within which zoospores form, especially when water is cooled to about 10°C below ambient temperature; in solid substrates, sporangia usually germinate by germ tubes
only rarely in solid media (CA) but readily though not abundantly when CA plugs are flooded with nonsterile soil extract water after 24–48 hours of incubation at 20°C.
Asexual phase
SporangiaSporangia:
sac within which zoospores form, especially when water is cooled to about 10°C below ambient temperature; in solid substrates, sporangia usually germinate by germ tubes
nonpapillatenonpapillate:
pertaining to the production of a non-distinct, or inconspicuous, papilla at the distal end of the sporangium (cf. papillate and semipapillate)
, persistentpersistent:
pertaining to sporangia that remain attached to the sporangiophore and do not separate or detach easily (cf. caducous)
; ovoidovoid:
egg-shaped, with the widest part at the base of the sporangium and the narrow part at the apex
, obpyriformobpyriform:
inversely pear-shaped, i.e. with the widest part at the point of attachment (cf. pyriform)
, ellipsoidellipsoid:
refers to a solid body that forms an ellipse in the longitudinal plane and a circle in cross section; many fungal spores are ellipsoidal or elliptic
(39–79 x 21–53 µm) proliferating internally in both a nested, never external proliferationexternal proliferation:
formation of a sporangium after a sporangiophore has emerged from beneath and external to an empty sporangium that has previously emitted its zoospores (cf. internal proliferation)
and originated on unbranched sporangiophores. Hyphal swellings globoseglobose:
having a rounded form resembling that of a sphere
, elongated, and catenulated. ChlamydosporesChlamydospores:
an asexual spore with a thickened inner wall that is delimited from the mycelium by a septum; may be terminal or intercalary, and survives for long periods in soil
absent.
Sexual phase
Homothallic. Oogonia ornamented (28–42 µm diam); antheridiaantheridia:
the male gametangium; a multinucleate, swollen hyphal tip affixed firmly to the wall of the female gametangium (the oogonium)
predominately paragynousparagynous:
pertaining to the sexual stage in which the antheridium is attached to the side of the oogonium (cf. amphigynous)
(11–20 x 9–18 µm); oospores slightly apleroticaplerotic:
pertaining to a mature oospore that does not fill the oogonium; i.e. there is room left between the oospore wall and oogonium wall (cf. plerotic)
(27–43 µm diam).
Additional specimen(s) evaluated
Phytophthora ornamentata ex-type CPHST BL 152, duplicate of P19906 (World Oomycetes/Phytophthora Collection), which is a duplicate of the ex-type CBS 140647
Hosts and distribution
Distribution: Europe (Italy)
Substrate: rhizosphere soil/roots
Disease Note: decline
Host: Pistacia lentiscus (Anacardiaceae)
Retrieved January 31, 2018 from U.S. National Fungus Collections Nomenclature Database.
Additional references and links
- SMML USDA-ARS: Phytophthora ornamentata
- EPPO Global Database: Phytophthora ornamentata
- Forest Phytophthora of the world: Phytophthora ornamentata
- CABI Digital Library: Phytophthora ornamentata
- Encyclopedia of Life (EOL): Phytophthora ornamentata
- Index Fungorum (IF): Phytophthora ornamentata
- Google All Phytophthora ornamentata
- Google Images Phytophthora ornamentata
- Google Scholar Phytophthora ornamentata
Fact sheet author
Z. Gloria Abad, Ph.D., USDA-APHIS-PPQ-S&T Plant Pathogen Confirmatory Diagnostics Laboratory (PPCDL), United States of America.